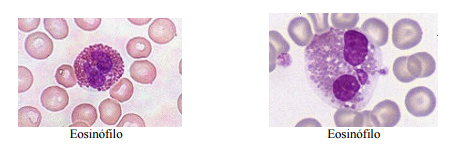
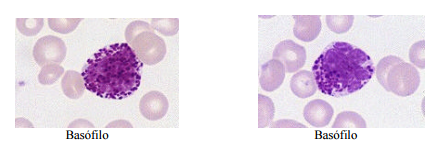
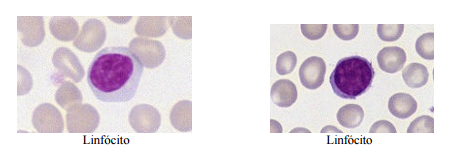
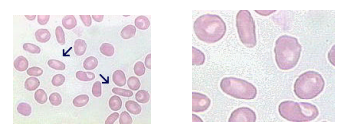
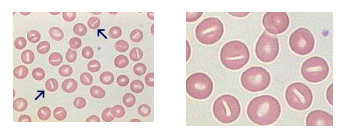
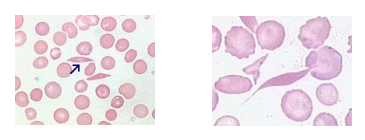
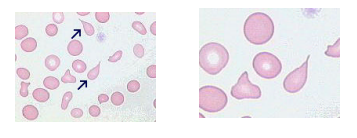
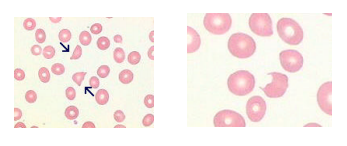
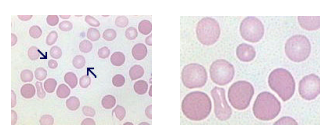
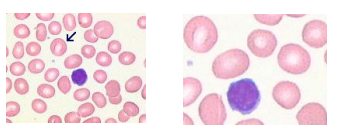
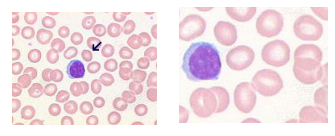
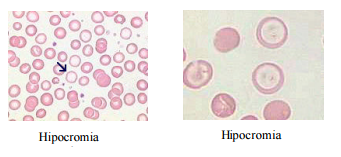
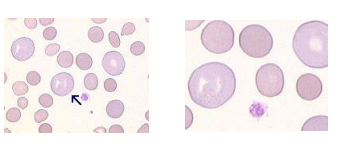
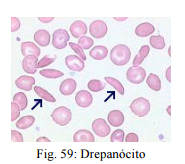

Noções de Hematologia
Noções Básicas em Enfermagem e o Processo de Cuidar
1 Hematopoiese:
A palavra hematopoiese significa formação das células do sangue. Abrange o estudo de todos os fenômenos relacionados com a origem, com a multiplicação e a maturação das células primordiais ou precursora das células sanguíneas, à nível da medula óssea.A hematopoiese se divide em dois períodos:
1.Período Embrionário e Fetal: Iniciando no primeiro mês de vida pré-natal, surgem as primeiras células fora do embrião, são os eritroblastos primitivos. Na sexta semana, tem início a hematopoiese no fígado; o principal órgão hematopoiético nas etapas inicial e intermediária da vida fetal. Na fase intermediária da vida fetal, o baço e os nodos linfáticos desempenham um papel menor na hematopoiese, mas o fígado continua a dominar essa função. Na segunda metade da vida fetal, a medula óssea torna-se cada vez mais importante para a produção de células sanguíneas.
2. Período Pós-natal: Logo após o nascimento, cessa a hematopoiese no fígado, e a medula passa a ser o único local de produção de eritrócitos, granulócitos e plaquetas. As células-tronco e as células progenitoras são mantidas na medula óssea. Os linfócitos B continuam a ser produzidos na medula e órgãos linfóides secundários e os linfócitos T são produzidos no timo e também nos órgãos linfóides secundários.
Ao nascer o espaço medular total é ocupado pela medula vermelha; na infância apenas parte desse espaço será necessária para a hematopoiese; o espaço restante fica ocupado pelas células de gordura. Mais tarde apenas os ossos chatos (crânio, vértebras, gradil torácico, ombro e pelve) e as partes proximais dos ossos longos (fêmures e úmeros) serão locais de formação de sangue.
2 Noções de Hematologia:
O sangue é a porção líquida do meio interno que circula rapidamente dentro de um sistema fechado de vasos denominado sistema circulatório. É constituído por um fluido no qual existem células em suspensão, moléculas e íons dissolvidos em água, apresentando propriedades das soluções coloidais.
Uma característica importante do sangue é a constância da sua composição química e propriedades físicas, assegurando condições físicas para o funcionamento das células. Ele é constantemente renovado pela entrada e saída de substâncias que modificam discretamente sua composição.
A constância da composição do sangue, com estreita faixa de variação, é o resultado mantido pela rapidez pela qual as substâncias deixam e entram no sangue quando estão em excesso ou em concentrações abaixo do normal respectivamente.
Composição do sangue:
O sangue é constituído de duas frações combinadas, sendo 55% para o plasma e 45% para as células.
A porção acelular ou plasma é constituído de 91,5% de água que serve de solvente das substâncias orgânicas e minerais e ainda de veículo para as células, moléculas e íons. Os restantes 8% são formados por proteínas, sais e outros constituintes orgânicos em dissolução.
A porção celular apresenta três tipos de células em suspensão no plasma:
• Glóbulos vermelhos, hemácias ou eritrócitos.
• Glóbulos brancos ou leucócitos.
• Plaquetas ou trombócitos.

Formação do sangue:
Plasma: é a porção fluida do sangue não coagulado; contém os fatores da coagulação, exceto aquele removido pelo anticoagulante; é formado às custas da ingestão de água, de alimentos, da difusão e trocas líquidas entre os vários compartimentos do organismo.
Soro: é a porção líquida amarelada do sangue que resta após a coagulação e remoção do coágulo. Não contém elementos celulares nem a maioria dos fatores da coagulação. Apresenta em solução sais minerais, vitamina, glúcides, prótides, lípides, enzimas, hormônios, produtos anabólicos e catabólicos, substâncias também encontradas no plasma.
A porção do sangue que não é o plasma ou seja , a parte celular, consiste de elementos figurados. Os elementos figurados incluem os eritrócitos (células vermelhas), vários tipos de leucócitos (células brancas) e plaquetas (trombócito).
3 Fisiologia dos eritrócitos e leucócitos:
Eritrócitos:
São células pequenas, circulares, com forma aproximada de discos bicôncavos, com 7,5 mm de diâmetro e sem núcleo. São os mais numerosos tios celulares no sangue. Embora seu número seja variável, um milímetro cúbico de sangue contém cerca de 4.5 a 6.1 milhões dessas células nos homens e cerca de 4.1 a 5.3 milhões nas mulheres. Essas células circulam pelo sangue circulante durante o período de aproximadamente 120 dias antes que sejam destruídas.

Hemoglobina:
É uma substância pigmentada, formada por duas partes: (1) porção que contém ferro denominada heme e (2) porção protéica, denominada globina. A globina consiste de quatro cadeias polipeptídicas, cada uma das quais ligada a um grupo heme. Cada grupo heme contém um átomo de ferro que se combina reversivelmente com uma molécula de oxigênio. Dessa forma, cada molécula de hemoglobina pode potencialmente associar-se com quatro moléculas de oxigênio. A principal função da hemoglobina e o transporte de oxigênio e gás carbônico, permitindo as trocas gasosas necessárias ao metabolismo orgânico.

Leucócitos:
São elementos figurados do sangue que estão envolvidos no sistema de defesa do organismo contra doenças e infecções. Por meio de fagocitose, eles defendem os tecidos contra invasão de organismos ou substâncias estranhas, removendo também os restos resultantes da morte ou de ferimentos celulares. Alguns leucócitos são capazes de passar através da parede intacta dos vasos chamada de diapedese; agindo assim principalmente no tecido conjuntivo frouxo.
São transportados pelo sangue para todo o corpo, a partir da medula óssea, onde são formados. Os leucócitos estão presentes no sangue em muito menor número que os eritrócitos, com cerca de 4.000 a 10.000 leucócitos por milímetro cúbico de sangue.
1. Neutrófilos: são conhecidos também como polimorfonucleares e correspondem cerca de 50 a 70% das células circulantes; possuem grânulos citoplasmáticos pequenos corados fracamente em púrpura-avermelhado. Os neutrófilos são capazes de deixar os vasos sanguíneos e entrar nos tecidos, onde protegem o corpo e fagocitando bactérias e substâncias estranhas ao organismo.
Existe uma célula precursora do neutrófilo segmentado, é o Bastão. São assim chamados porque seu núcleo não amadureceu completamente, embora seu citoplasma tenha características de célula madura. Em infecções bacterianas agudas pode-se encontrar um desvio a esquerda ,ou seja, uma elevação do número de bastões.

2. Eosinófilos: possuem grânulos corados em laranja-avermelhado e fagocitam complexos antígeno-anticorpo. Seus núcleos geralmente têm dois lobos conectados por um filamento. O número de eosinófilos circulantes aumenta de forma muito acentuada no sangue circulante durante as reações alérgicas, e durantes as infestações parasitárias.
3. Basófilos: possuem grânulos relativamente grandes corados em azul púrpura; liberam histamina (contribui para as respostas alérgicas dilatando e permeabilizando os vasos sanguíneos) e heparina (previne a coagulação do sangue).Os basófilos funcionam similarmente aos mastócitos, que são encontrados no tecido conjuntivo.
4. Monócitos: possuem um único núcleo; são células grandes. São formados por monoblastos; São capazes de entrarem no tecido conjuntivo frouxo, onde se desenvolvem em grandes células fagocíticas denominadas macrófagos, que podem ingerir bactérias e outras substâncias estranhas ao organismo.

5. Linfócitos: são o segundo tipo mais abundante de leucócitos( após os neutrófilos), compreendendo cerca de 30% dos glóbulos brancos em circulação; a maioria se localiza no tecido linfoide e são formados por linfoblastos. São leucócitos pequenos, sendo apenas um pouco maiores que os eritrócitos, e cada um deles tem um núcleo que é circular ou algo recortado num dos lados. São importantes nas respostas imunes específicas do corpo, incluindo a produção de anticorpos.
4 Hemograma completo:
Eritrograma:
Constitui o estudo da séria vermelha, revelando alguns tipos essenciais de alterações patológicas do sistema eritropoético como eritrocitoses e anemias.
Contagem de hemácias na câmara de Neubauer:
Os métodos para contagem global das células sanguíneas consistem geralmente em diluir o sangue, em proporção conhecida, com um líquido diluidor chamado Hayem, permitindo a conservação das células em estudo.
1. Pipetar 4 ml do líquido diluidor em um tubo de ensaio.
2. Com a pipeta transferir 0,02 ml de sangue. Limpar a parede externa da ponteira com auxílio de papel absorvente.
3. Transferir os 0,02 ml de sangue para o tubo com o líquido diluidor, lavando com ele o interior da ponteira por aspiração e expulsão do líquido. A diluição é de 1:200.
4. Agitar suavemente por inversão para uma correta homogeneização.
5. Com uma pipeta preencher os retículos da câmara de contagem, evitando excesso de líquido e bolhas de ar sob a lamínula aderida firmemente à câmara.
6. Deixar repousar por dois minutos para sedimentação dos glóbulos.
7. Focalizar a preparação com pequeno aumento no microscópio para localizar o retículo e observar a distribuição uniforme das hemácias. Observar então, com aumento de 100X ou 400X, conforme necessidade.
8. Fazer a contagem de todas as hemácias encontradas nos quadros marcados “H” na figura relativa ao retículo de Neubauer, ou seja, 1/5 de mm2 . Sistematizar a contagem segundo a figura abaixo. Contar os elementos em negro.

Cálculos: Hemácias por ml de sangue = H.c. x 5 x 10 x 200
Dosagem da hemoglobina pelo método da cianometemoglobina:
É o método de referência para a dosagem de hemoglobina. Dosam todas as suas formas exceto a sulfemoglobina. A desvantagem reside na extrema toxidade do cianeto usado no preparo do reagente (solução de Drabkin), mas pode ser resolvida pela aquisição já preparada, de concentração mínima.
Temos usado, com bons resultados, os reagentes Labtest; a solução de Drabkin modificada e o padrão de hemoglobina de concentração conhecida. Calcula-se um fator determinado a absorbância de 0,02 ml do padrão em 5ml da solução de cianeto, através da fórmula:

O zero é estabelecido com água destilada em 540nm. O sangue em estudo, diluído de modo idêntico a padrão (0,02 ml para 5 ml de Drabkin) fornece outro valor de absorbância, que multiplicando pelo fator de g% de hemoglobina pela multiplicação de cada unidade de leitura pelo fator. Hb = Absorbância do paciente X Fator.
Determinação do hematócrito pelo método do microhematócrito.
Hematócrito é o volume de hemácias expresso como percentagem do volume de uma amostra de sangue total, ou seja, mililitros de hemácias por decilitro de sangue.
Determinação do microhematócrito:
1. Encher com o sangue o tubo para microhematócrito, até dois terços do seu volume. Para tubos heparinizados o sangue capilar pode ser usado.
2. Selar o tubo, introduzido a extremidade vazia na massa própria, com movimentos de rotação, até aproximadamente 5mm de profundidade.
3. Encher os demais tubos de modo idêntico.
4. Coloca-os na microcentrifuga em posição diametralmente opostas com a parte selada voltada para fora. Observar a numeração evitando a troca de resultados.
5. Após tampar convenientemente a microcentrifuga, coloca-a em movimento por cinco minutos. Tempo superior a este não altera a sedimentação dos glóbulos.
6. Desligar o aparelho. Retirar os tubos e fazer a leitura usando a escala própria.
Leitura dos resultados:
1. Colocar o tubo sobre a escala, fazendo coincidir a extremidade inferior das células centrifugadas com a linha zero.
2. Deslocar o tubo paralelamente às linhas verticais fazendo coincidir o menisco superior do plasma com a linha 100.
3. Ler a percentagem do volume hematócrito na escala graduada ao nível da superfície das hemácias no tubo.
Índices hematimétricos:
Índices hematológicos ou hematimétricos são determinados a partir da contagem global dos eritrócitos, taxa de hemoglobina e determinação do hematócrito. Tais elementos, deverão ser padronizados pelo laboratório, fornecendo-se sempre resultados na unidade de percentagem do normal.
V.C.M – Volume corpuscular médio:
É o volume médio das hemácias expresso em fentolitros. Representa, portanto, o quociente de um determinado volume de hemácias pelo número de células contidas no mesmo volume.

H.C.M. – Hemoglobina corpuscular média:
É o conteúdo médio de hemoglobina nas hemácias expresso em picogramas. Representa, portanto, o quociente de conteúdo de hemoglobina em um determinado volume de hemácias pelo nº de células contidas no mesmo volume.

C.H.C.M. – Concentração de hemoglobina corpuscular média:
É a percentagem de hemoglobina em 100ml de hemácias.

5 Hemograma completo Parte 2:
Leucograma:
O leucograma corresponde a contagem global e específica dos leucócitos, representados pela leucometria e pelo estudo quantitativo e qualitativo dos glóbulos brancos. O quadro leucocitário que se apresentará após ser concluído o exame hematológico, permitirá ao médico tirar conclusões diagnósticas e prognósticas importantes.
Contagem global de leucócitos com câmara de Neubauer:
1. Pipetar 0,4 ml do líquido de Turk no tubo
2. Com pipeta automática, pipetar 0.02 ml de sangue.Limpar a ponteira com papel de filtro.
3. Transferir os 0,02 ml de sangue para o tubo com o líquido diluidor, lavando com ele o interior da pipeta por aspiração e expulsão do líquido. A diluição é de 1:20.
4. Agitar suavemente por dois minutos.
5. Encher os dois retículos da câmara de contagem, evitando excesso de líquido e bolhas de ar sob a lamínula, aderida firmemente à câmara por compressão daquela sobre esta, cobrindo ambos os retículos.
6. Deixar repousar de um a dois minutos para sedimentação dos glóbulos.
7. Focalizar a preparação com pequeno aumento no microscópio para localizar o retículo e observar a distribuição uniforme dos leucócitos. Em seguida, observar com aumento de 100 x ou 400 x, a desejar.
8. Fazer a contagem de todos os leucócitos encontrados nos quadros marcados “L” na figura relativa de Neubauer,ou seja, 4mm2 . (Fig.12)

Leucócitos global = ? de leucócitos X 50.
Forma Leucocitária Relativa:
Determina a relação percentual entre as distintas variedades de leucócitos. Se, em 100 leucócitos contados no esfregaço, 60 são neutrófilos, estes representam 60% do total de leucócitos.
Forma Leucocitária Absoluta:
Fornece o número de cada tipo de leucócito por micro-litro de sangue. Considerando para o caso anterior que a contagem global de leucócitos foi de 8.000 por micro-litro de sangue, uma relação pode ser estabelecida:
- Em 100 leucócitos, 60 são neutrófilos. Em 8.000 leucócitos, 4.800 serão neutrófilos. Dessa forma, um micro-litro de sangue contém 4.800 neutrófilos.
Para cada um dos tipos contados o mesmo raciocínio será seguido, estabelecendo a fórmula leucocitária relativa e absoluta para todas as variedades de leucócitos.
6 Alterações do eritrograma Parte 1:
Anemias:
Anemia é a diminuição da taxa de hemoglobina abaixo de níveis mínimos, ou seja, se estiver abaixo de 95% do intervalo de referência para idade, sexo e localização geográfica (altitude) do indivíduo.
As causas de anemias se encontram divididas entre três categorias fisiológicas principais: produção de eritrócitos deficientes, perda sanguínea ou destruição acelerada dos eritrócitos (hemólise) além da capacidade da medula de compensar estas perdas.

RDW / ( red blood cell distribution width = amplitude de distribuição dos eritrócitos):
É um subproduto da medida eletrônica do volume dos eritrócitos; ou seja, só pode ser detectado através da automação. O seu valor normal está entre 11 e 14 %. Valores encontrados abaixo do normal indicariam população eritróide mais homogênea que a usual, o que parece ser apenas um extremo da normalidade. Valores acima de 14 indicam excessiva heterogeneidade da população (anisocitose), sendo notada ao microscópio.
Segundo Failace,se houver anemia e/ou índices hematimétricos anormais, o profissional deverá:
1. Confirmar visualmente as alterações numéricas e julgar sua compatibilidade com o grupo etário do paciente.
2. Pesquisar os dados morfológicos das células do paciente.
3. Nada observando de esclarecedor, os resultados numéricos e a lâmina do paciente são separados para reexame; se a distensão não estiver perfeita, faz-se uma nova. As principais alterações morfológicas a serem avaliadas são:
Pecilocitose: também conhecida como poiquilocitose, diz respeito à presença de formas anormais dos eritrócitos. Deve ser sempre mencionado quando observado na lâmina. O melhor é definir cada um dos aspectos celulares notados através de suas características morfológicas.

Dentre as principais formas anormais existentes, temos:
• Eliptócitos ou ovalócitos: são eritrócitos ovais, elípticos ou com forma de charutos; são mais abundantes em casos de eliptocitose hereditária. Podem ser observados em anemia microcíticas e megaloblásticas e nas síndromes mieloproliferativas.
• Estomatócitos: são eritrócitos cuja membrana retraiu-se em cúpula; distendidos na lâmina, a concavidade unilateral é vista como uma fenda alongada. A estomatocitose é geralmente um artefato de preparação das zonas delgadas da distensão de sangue; há estomatócitos nas doenças hepáticas e no sangue do recém nascido.
• Esferócitos: são eritrócitos praticamente esféricos, em contradição com os discos bicôncavos normais. Seu diâmetro é menor que o normal e não possuem a área central pálida. Esferócitos são encontrados em casos de esferocitoses hereditária, anemias hemolíticas auto-imune.

• Drepanócitos ou eritrócitos falciformes: são eritrócitos que decorrentes da hemoglobina S, têm a forma de foice ou banana, caracterizando as síndromes falcêmicas.
• Dacriócitos: são eritrócitos em forma de lágrima.Deformam-se principalmente no baço, ao passarem pelas fenestrações entre cordões e sinus medulares; Encontrados em anemias megaloblásticas e mieloesclerose.
• Esquizócitos: são pedaços de eritrócitos, cortados pelo trauma; podem ser triangulares, em meia lua, etc. Tem curta sobrevida no sangue.Indicam presença de hemólise, anemia megaloblástica, queimaduras graves.
• Células-alvo: são eritrócitos mais delgados que o normal (leptócitos), e que, quando corados, exibem uma borda periférica de hemoglobina com uma área central escura, contendo hemoglobina. São encontradas em caso de obstrutiva, em qualquer tipo de anemia hipocrômica, sobretudo na talassemia.

• Equinócitos: também conhecidos como hemácias crenadas, podem ocorrer como artefatos durante a formação dos esfregaços. In vivo, podem ser vistos na uremia, no hipotireoidismo, no tratamento com heparina IV.

Anisocitose:
É uma característica da maioria das anemias; quando ocorre em grau significativo, habitualmente estarão presentes tanto macrócitos e/ou micrócitos.É de suma importância para o clínico que seja relatado no laudo a predominância da forma na anisocitose.
Macrocitose:
É a elevação do VCM acima de 98 ( ou 100 ) fL . Segundo Failace, a macrocitose só é notada quando houver uma população normocítica ou microcítica concomitante; ou quando o VCM estiver acima de 110 fL.
Condições onde pode ser encontrada a macrocitose:
• Alcoolismo: o VCM nunca excede 110fL e os eritrócitos são redondos, de aspecto normal.
• Uso de drogas: AZT (atualmente lidera a estatística das drogas causais); os macrócitos são redondos costumando haver anemia; o RDW é elevado.
• Anemia aplástica: na maioria dos casos há macrocitose; persiste mesmo após recuperação, se houver.
• Hepatopatias: há macrocitose com rouleux, leptocitose, acantocitose.
• Esplenectomia: causa macrocitose em pequenas percentagem de pacientes.
• Anemias megaloblásticas: os macrócitos são ovalados e enormes. O VCM se encontra entre 110 e 130 fL porque há anisocitose e pecilocitose acentuadas.
• Hiper-regeneração eritróide: é causa comum de macrocitose, notada pelos macrócitos polocromáticos e confirmada pela coloração de reticulócitos.
Microcitose:
A microcitose representa uma evidência morfológica de uma capacidade diminuída dos precursores das hemácias de produção de hemoglobina. Isto pode resultar de ferro insuficiente como na anemia ferropriva; através de defeitos genéticos hereditários como nas síndromes talassêmicas, etc.
Assim a microcitose pode ser encontrada quando o VCM se encontra abaixo de 80 fL; porém, segundo Failace, ela só é notada ao microscópio quando está abaixo de 70 fL, ou quando há uma população normo ou macrocítica contrastante.
7 Alterações do eritrograma Parte 2:
Condições onde pode ser encontrada a microcitose:
• Grupo etário: é normal ser encontrada a microcitose na infância.
• Anemia ferropênica: a microcitose é proporcional ao grau de anemia,ou seja, quanto mais acentuada a anemia ferropênica maior será a microcitose.
• Anemia das doenças crônicas: Costuma ser normcítica, mas pode ser microcítica como na artrite reumatóide.
• Hemoglobinopatias: Em todas as hemoglobinoptias pode haver micro ou normocitose; sempre há outras características morfológicas sugestivas do defeito.
• Ovalocitose: é normal ser encontrada a microcitose.
• Talassemia minor: Há uma acentuada microcitose com o VCM muito baixo e a contagem de eritrócitos muito alta.
Hipocromia:
É a redução da coloração do eritrócito; há um aumento da palidez central, que ocupa a área superior ao terço do diâmetro do eritrócito. A hipocromia pode ser geral ou pode existir em algumas células do paciente. Esta característica pode ser retratada através da redução do CHCM.
Qualquer uma das condições que leva a microcitose pode causar hipocromia, embora alguns paciente com anemias como b-talassemia a distensão sanguínea apresenta microcitose sem hipocromia.
Policromatocitose:
São eritrócitos acinzentados ou azulados considerados uns dos dados mais importantes na microscopia do sangue anêmico. Não é notada pela automação e é fundamental para a interpretação. A policromatocitose está presente também após o 40 rit na regeneração pós-hemorrágica, sempre nas anemias hemolíticas.
Eritroblasto:
São eritrócitos nucleados que aparecem no sangue no decurso de grandes regenerações eritróides, principalmente em crianças, acompanhando a policromatocitose; como também em sangue do recém-nascido, na primeira semana.
Os eritroblastos circulantes podem apresentar uma freqüência aumentada nas intoxicações por chumbo, e em certos estados diseritropoéticos , como na eritroleucemia, e emsmo na anemia ferropenica grave.

Os eritroblastos são contados como leucócitos nos contadores eletrônicos. Quando ultrapassam 5% justifica-se desconta-los na contagem de leucócitos. Essa correção deve ser feita através da seguinte fórmula:

8 Alterações do leucograma:
Em processos infecciosos agudos três fases são desenvolvidas:
A. Fase Neutrofílica ou Luta:
Leucocitose com Neutrofilia, desvio à esquerda, eosinopenia e linfopenia.
B. Fase Monocítica ou Defesa:
Leucocitose com Neutrofilia ou normal, monocitose, eosinopenia e linfopenia.
C. Fase Linfocitária ou Cura:
Leucócitos normais ou elevados, neutropenia, ausência e desvio a esquerda, linfocitose com presença de eosinófilos normais ou elevados.
Neutrocitose ou Neutrofilia:
É a elevação da contagem absoluta de neutrófilos acima da que seria considerada normal em um indivíduo sadio de mesmo sexo, idade, raça e estado fisiológico. São causas de neutrofilia:
• Neutrofilia hereditária.
• Infecções: Muitas infecções bacterianas agudas e crônicas incluindo a tuberculose miliar; algumas infecções virais como varicela, herpes simples, raiva, poliomielite; algumas infecções fúngicas como a actinomicose; algumas parasitoses como amebíase hepática, a filaríase.
• Dano tecidual como trauma, cirurgia, queimaduras, necrose hepática aguda, pancreatite aguda.
• Infarto tecidual como infarto agudo do miocárdio, infarto pulmonar.
• Inflamação aguda e crônica grave como na gota, febre reumática, artrite reumatóide, colite ulcerativa.
• Hemorragia aguda.
• Hipóxia aguda.
• Doenças malignas como carcinoma, sarcoma.
• Leucemias e síndromes mieloproliferativas.
• Administração de drogas como corticóides, o lítio.
• Intoxicações por agentes químicos.
• Envenenamentos como picada de escorpião ou ataque de abelhas.
• Tabagismo.
• Exercício vigoroso.
• Dor aguda, convulsões epilépticas, eclampsia e pré-eclampsia.
Neutropenia ou Neutrocitopenia:
É a diminuição do número absoluto de neutrófilos; pode ser um fenômeno isolado ou fazer parte de uma pancitopenia.São causas de neutropenia:
• Agranulocitose: síndrome caracterizada pela diminuição severa e passageira dos neutrófilos do sangue, com preservação das demais séries.
• Infecções virais como sarampo, caxumba, rubéola, dengue,infecção pelo HIV.
• Infecções bacterianas como febre tifóide, brucelose.
• Infecções por protozoários como a malária, o calazar, a tripanossomíase.
• Irradiação.
• Anemia megaloblástica e anemia aplástica.
• Hiperesplenismo.
• Alcoolismo.
9 Alterações do leucograma Parte 2:
• Hipertireoidismo.
Eosinofilia:
É o aumento do número absoluto de eosinófilos, ultrapassando o número de referência. É um achado comum nos hemogramas em laboratórios que atendem população de baixo nível sócio-econômico.São causas de eosinofilia:
• Doenças alérgicas como eczema atópico, asma, rinite elérgica, urticária aguda.
• Hipersensibilidade medicamentosa comosulfonamidas, penicilinas.
• Infecções parasitárias(particularmente quando há invasão tecidual) como esquistossomose, estrongiloidíase, ascaridíase, ancilostomíase, cisticercose, toxocaríase.
• Doenças cutâneas como o pênfigo, o penfigóide bolhoso, o herpes gestacional. As micoses superficiais não causam eosinofilia significativa.
• Eosinofilia hereditária.
• Eosinofilia na leucemia mielóide crônica.
• Eosinofilia sem causa aparente.
Eosinopenia:
É a redução da contagem de eosinófilos abaixo da que seria esperada em um indivíduo da mesma idade. A eosinopenia é raramente notada na distenção sanguínea de rotina, pois o limite inferio é muito baixo.São causas de eosinofilia:
• Estresse agudo, incluindo trauma cirurgia, queimaduras, convulsões epileptiformes,inflamação aguda,infarto do miocárdio, drogas incluindo os corticóides.
Linfocitose:
É o aumento do número absoluto de linfócitos. Uma vez que as contagens de linfócitos em lactentes e crianças são consideravelmente mais altas que as dos adultos, é muito importante usar a faixa de referência adaptada a idades.São causas de linfocitose:
• Infecções virais, incluindo: sarampo, rubéola, caxumba, influenza, hepatite infecciosa, mononucleose infecciosa, linfocitose infecciosa, citomegalovirose
• Linfocitose transitória relacionada com o estresse.
• Esplenectomia
• Reações alérgicas a droga
• Leucemia linfóide
Linfopenia:
É a redução da contagem de linfócitos. A linfopenia é extremamente comum como parte resposta aguda ao estresse; sua detecção é mais provável quando se faz uma contagem diferencial automatizada e quando as contagens são expressas em números absolutos. São causas de linfopenia:
• Insuficiência renal incluindo aguda e crônica
• Carcinoma
• AIDS - estágio final da doença
• Irradiação
• Alcoolismo
• Artrite reumatóide e lúpus eritematoso sistêmico
• Anemia ferropênica
Monocitose:
É o aumento do número de monócitos acima do seria esperado em um indivíduo sadio da mesma idade. O número absoluto de monócitos é mais elevado nos recém-nascidos que nos outros períodos da vida.São causas de monocitose:
• Infecção crônica, incluindo a sífilis
• Condições inflamatórias crônicas (colite ulcerativa, artrite reumatóide e o lúpus eritematoso sistêmico)
• Carcinoma
10 Alterações do leucograma Parte 3:
• Condições leucêmicas e mieloproliferativas
• Hemodiálise à longo prazo
• Leishmaniose e Hanseníase
• Tuberculose
Basofilia:
É comum observar um aumento acentuado nas contagens de basófilos nas desordens mieloproliferativas, em algumas leucemias e em choque anafilático.Porém a observação de basopenia não tem sido considerada de importância diagnóstica.
11 Hemostasia e coagulação:
Hemostasia é o processo pelo qual o sangue permanece líquido vascular, apesar das lesões que venham a sofrer.
A hemostasia resulta de uma série de interações complexas pelos quais o sangue é mantido fluido no sistema vascular; são prevenidos processos hemorrágicos espontâneos e contidos sangramentos traumáticos. Depende basicamente da resistência e contratilidade normais dos vasos, da atividade plaquetária normal, de um sistema adequado de coagulação e da estabilidade do coágulo. Com o processo de coagulação do sangue é obtido um coágulo sólido de fibrina através da interação de plaquetas, fatores plasmáticos, seus inibidores e ativadores. Quando há lesão de um vaso sanguíneo, o sistema hemostático intervem imediatamente. Inicialmente, há vasoconstricção reflexa reduzindo o fluxo sangüíneo local. Em seguida, as plaquetas se predem às fibras de colágeno do tecido conectivo exposto no processo chamado de adesão e uma às outras no processo de agregação, amplificado pela liberação de substâncias intraplaquetárias armazenadas em grânulos ocorrendo a formação do tampão hemostático. Este fenômeno é regulado pelo nível de AMP cíclico presente no interior das plaquetas que é derivado do ATP pela ação da fosfodiesterase.
Concomitantemente, através das vias extrínseca e intrínseca, a partir de fatores plasmáticos, ocorre a ativação de protrombina em trombina que atua sobre o fibrinogênio para formar a rede de fibrina que é estabilizada pela ação do fator XIII com a formação de um coágulo sólido.
Posteriormente, ocorre a lise deste coágulo pelo sistema fibrinolítico, onde o plasminogênio é ativado à plasmina, dividindo a molécula em um série de produtos conhecidos como produtos de degradação de fibrina. Ocorre assim a reparação do local lesado e o restabelecimento do fluxo sanguíneo normal.
Distúrbios adquiridos ou hereditários (na maioria das vezes deficiências de um único fator – grupo das hemofilias) destes sistemas fisiológicos ocasionam doenças hemorrágicas ou trombose.
No processo de coagulação do sangue tomam parte várias substâncias denominadas fatores da coagulação. Muitos deles são pró-enzimas sintetizadas pelo fígado e que se transformam em enzimas durante o processo de coagulação.
Coagulação é a conversão do sangue no estado líquido em um coágulo firme. É a fase da hemostasia envolvida na formação de fibrina, sendo caracterizada por uma série sucessiva de reações bioquímicas e fenômenos físicos, terminando fisiologicamente com a formação do coágulo.
A hemostasia é regulada por três tipos de mecanismos:
1. Os extravasculares incluem a constituição e a elasticidade dos tecidos na periferia dos vasos.
2. Os vasculares relacionam-se à elasticidade e tônus da parede vascular.
3. Os intravasculares são principalmente aqueles associados à substâncias envolvidas no processo de coagulação do sangue.
Uma série de respostas ocorre em consequência da lesão do vaso sanguíneo. Inicialmente a vasoconstrição reflexa diminui o sangramento e as plaquetas se aglutinam, aderindo à superfície do ferimento a elas expostas. Em seguida, a deposição de fibrina forma o coágulo que se retrai e se organiza na região rota. Posteriormente ocorre a lise da fibrina com recanalização do vaso.
No processo da coagulação do sangue tomam partes várias substâncias denominadas fatores da coagulação. Muitos deles são pró-enzimas sintetizadas pelo fígado e que se transformam em enzimas durante o processo de coagulação.
Causas das Hemorragias e investigação laboratorial:
As hemorragias podem resultar da solução de continuidade ou defeitos do sistema vascular, deficiência qualitativa ou quantitativa de plaquetas, defeitos químicos ou quantitativos dos fatores da coagulação e anticoagulantes circulantes. Usualmente a combinação dos vários mecanismos leva ao sangramento anormal nas doenças adquiridas, enquanto nas congênitas o defeito é geralmente único.
Como exemplo de condições favoráveis às hemorragias, encontram-se : menstruação, úlceras do trato gastrointestinal, cirurgias, traumatismos, números reduzidos de plaquetas circulantes e ausência congênita ou adquirida de fatores da coagulação.
O significado clínico das hemorragias depende de três fatores:
1. Quantidade de sangue perdido - Perdas súbitas entre 10 a 20% do volume total geralmente não apresentam significado clínico. Volumes maiores perdidos rapidamente podem levar ao choque hipovolêmico.
2. Local da hemorragia – Reveste-se de importâncias aquelas, mesmo pequenas, localizadas no pericárdio, supra-renais e cérebro, podendo levar a morte súbita.
3. Duração da hemorragia. As agudas têm características descritas no item 1. As crônicas correspondendo a pequenos volumes de sangue perdidos intermitentemente, levam a anemias por deficiência do ferro, quando o sangue elimina-se externamente. Se no interstício ou cavidades do organismo, o ferro é reabsorvido não ocorrendo a anemia ferropriva.
O estudo laboratorial da hemostasia é baseado em provas cujo objetivo consiste em evidenciar a presença ou ausência de fatores da coagulação ou causas adversas, relacionadas a mecanismos vasculares, extravasculares e intravasculares da coagulação.

Tempo de Sangramento (Método de Duke):
O tempo de sangramento corresponde à duração de uma pequena hemorragia quando uma incisão de dimensões padronizadas é praticada na pele artificialmente. O teste fornece dados relativos a função e números de plaquetas, bem como da resposta da parede capilar à lesão. Tempo de sangramento aumentado sugere a complementação do estudo pela contagem das plaquetas.
Técnica:
1. Fazer a assepsia do lóbulo da orelha ou polpa digital com álcool. Escolher o local da picada evitando áreas congestas e inflamadas.
2. Com a lanceta, fazer uma incisão de três milímetros de profundidade, permitindo que o sangue escoe livremente.
3. Fazer funcionar o termômetro no momento da picada.
4. Usando papel de filtro secar de 30 em 30 segundos a gota de sangue que se forma sem, no entanto, tocar a lesão, utilizando cada vez uma porção limpa do papel.
5. Quando o sangue para de manchar o papel, parar o cronômetro; é o valor do TS.
Valor Normal: entre 1 a 4 minutos.
Tempo de Coagulação (Método de Lee - White)
O tempo de coagulação corresponde o tempo gasto para o sangue coagular, quando registrado no organismo.Fornece dados relativos ao sistema de coagulação do sangue .É um teste sujeito a numerosas variáveis e que atualmente deve ser substituído pelo tempo de tromboplastina parcial.
12 Hemostasia e coagulação Parte 2:
Técnica:
1. Colher o sangue por punção venosa, atingindo diretamente a veia. Os fatores teciduais alteram o processo de coagulação e até invalidam a prova.
2. Marcar o tempo no cronômetro logo que o sangue aparecer na seringa.
3. Tomar dois tubos e colocar 1,0ml de sangue em cada um deles.
4. Colocar os tubos em banho-maria a 370C até completar cinco minutos.
5. Após os cinco minutos marcados verificar se houve a formação do coágulo inclinando o tubo numa angulação de 90o ;se não houver coagulado, verificar a cada minuto até a sua formação.
6. Marcar o tempo da formação do coágulo como tempo de coagulação do sangue total.
Valor Normal: de 5 a 11 minutos.
Medida de Retração do Coágulo:
A percentagem de retração do coágulo é representada pelo volume do soro obtido, após coagulação e retração do coágulo, de uma quantidade determinada de sangue. O coágulo inicial contém todos os elementos do sangue. Após sua retração o soro é expulso da malha de fibrina, que se retrai pela ação das plaquetas. Fornece dados relativos à atividade plaquetária. Uma retração pequena corresponde a um número de plaquetas abaixo de 100.000 por ml de sangue.Nas deficiências funcionais das plaquetas, a prova pode estar alterada em presença de número normal ou aumento de plaquetas.
Técnica:
1. Colher um pouco mais de 5ml de sangue por punção venosa.
2. Encher o tubo de centrífuga até a marca 5ml.
3. Colocar o fio de cobre, fixo pela rolha, com extremidade encurvada mergulhada no sangue até a metade da coluna líquida.
4. Determinar a coagulação do sangue, inclinando o tubo, como para tempo de coagulação.
5. Colocar então o tubo em banho-maria a 370C durante uma hora.
6. Retirar cuidadosamente o coágulo aderido ao fio de cobre através da rolha. Deixar escorrer o líquido existente no coágulo por um a dois minutos.
Cálculos:
O volume de soro expresso como porcentagem de 5ml de sangue total representa a porcentagem de retração do coágulo. Se em 5ml de sangue total são obtidos 2ml de soro, em 100ml de sangue são obtidos x ml de soro.

Atualmente os laboratórios adaptaram uma nova técnica para a leitura da retração do coágulo; através do aproveitamento do tubo utilizado no tempo da coagulação é feita também a retração do coágulo. É marcada uma hora após a realização do TC com o tubo no banho a 37oC depois, utilizando uma pipeta volumétrica de 1 ml, todo o soro do tubo é aspirado. O volume aspirado do volume total é considerado o valor da retração do coágulo. Ex: se for aspirado 0,4 ml de soro, então a retração do coágulo tem como resultado 40%. Porém esta técnica não foi encontrada em literaturas.
Prova de Resistência Capilar ou Prova do Laço (Rumpel-Leed):
O sangue é normalmente retido no leito capilar devido à resistência oferecida pela parede destes finos vasos. A permeabilidade capilar alterada permite a passagem das células do sangue para os tecidos. Isso é evidenciado pelo aparecimento de petéquias na pele. O número e tamanho das petéquias dependem da estrutura do endotélio capilar e número de plaquetas por microlitro de sangue.
Técnica:
1. Verificar a presença de petéquias no braço do paciente. Caso existam, contorna-las com lápis dermográfico.
2. Adaptar o manguito do aparelho de pressão ao braço do paciente.
3. Determinar a pressão diastólica e mantê-lo insuflado nessa pressão durante 5 minutos.
4. Desinsuflar rapidamente o manguito. Verificar o aparecimento e contar o número de petéquias formadas durante o teste.
resultados:
O resultado é fornecido conforme o número e tamanho da s petéquias.Com afinidade de estabelecer uma uniformização para a leitura da prova, os seguintes resultados são convencionados:
Negativo: nenhuma ou no máximo seis petéquias puntiformes no limite onde foi colocado o manguito.
Positivo +: de 6 a 50 petéquias puntiformes isoladas localizadas na região da fossa antecubital.
Positivo ++ : inúmeras petéquias puntiformes isoladas e localizadas na fossa antecubital, antebraço e raras na mão.
Positivo +++ : petéquias de dois a quatro milímetros com a mesma localização anterior e confluente em algumas áreas.
Positivo ++++ : petéquias maiores que as anteriores localizadas em to a área de estase, confluentes em alguns pontos, dando ao membro coloração violácea.
Determinação do Tempo de Protrombina (TP):
Ao plasma descalcificado pelo citrato, é adicionado um excesso de tromboplastina. Considerando que protrombina é convertida em trombina num tempo uniforme, a recalcificação com qualidade conhecida de cloreto de cálcio produz a coagulação do plasma.
O tempo, em segundos, anotado desde a recalcificação até a coagulação é o tempo de protrombina. A prova determina a atividade da protrombina no sangue.
13 Hemostasia e coagulação Parte 3:
Técnica:
1. Colocar o tubo com 0,2 ml de tromboplastina cálcica em banho-maria a 370C marcando 2 min.
2. Colocar outro tubo 0,2ml de plasma citratado marcando mais 2 min.
3. Acrescentar 0,1ml do plasma aquecido no tubo contendo a tromboplastina também aquecida., adicionar imediatamente o cronômetro e ao mesmo tempo agitar o tubo no banho até 7 segundos
4. Retirar o tubo do banho e invertê-lo a cada segundo até verificar o momento da recalcificação do plasma através da formação do coágulo e parar imediatamente o cronômetro. O tempo gasto em segundos para ocorrer a coagulação é o Tempo de Protrombina.
Interpretação: A determinação do TP constitui prova de grande valor na avaliação da hemostasia, analisando os fatores extrínsecos da coagulação. Diagnóstico da coagulação intravascular disseminada. Controle de terapêutica heparínica e fibrinolítica. O seu tempo está prolongado em paciente em uso de heparina, depleção do fibrinogênio, doenças hepáticas, paraproteínas e disfibrinogenemias.
Tempo de Tromboplastina Parcial Ativado (TTPa):
Em princípio esta prova é semelhante ao tempo de protrombina. Envolve a recalcificação do plasma, porém em presença de uma cefalina proveniente de um extrato etéreo de cérebro. A cefalina é uma lipoproteína. Funciona como substituto das plaquetas, fornecendo uma concentração ótima de fosfolípede.
O tempo de tromboplastina parcial corresponde ao tempo gasto para ocorrer a coagulação do plasma recalcificado em presença de um fosfolípede ou tromboplastina parcial.
Técnica:
1. Em um tubo de ensaio de 12 x 75mm aquecido a 370C, colocar 0,1ml de plasma normal e 0,1ml de cefalina-caolin.
2. Agitar uma vez e incubar a 370C por três minutos.
3. Após os 3 min. adicionar 0,1 ml da solução de cloreto de cálcio rapidamente e ao mesmo tempo fazer funcionar o cronômetro. O cloreto de cálcio tem que estar pré aquecido por pelo menos 5 min.
4. Agitar no banho por 25 segundos. Retirar o tubo do banho-maria e invertê-lo a cada segundo, observando o momento em que houver a coagulação. Neste instante parar o cronômetro. O tempo gasto em segundos para ocorrer a coagulação é o tempo de tromboplastina parcial.
5. Expressão dos resultados.
Interpretação: É o melhor dos testes para ser usado nas triagens de defeitos da coagulação (via intrínseca). Controle de heparinização. O tempo está prolongado nas deficiências de um ou mais fatores (I,II, V, VII, IX, XI e XII) e no uso terapêutico de heparina ou na presença de anticoagulantes circulantes.
Contagem de plaquetas:
Devido ao seu pequeno tamanho, sua tendência a aderir a superfícies estranhas ao endotélio vascular e sua rápida desintegração, a contagem de plaquetas torna-se problemática por qualquer método.
As plaquetas são contadas por métodos diretos e indiretos. Nos métodos diretos elas são visualizadas em uma diluição do sangue e contadas na câmara de Neubauer através da microscopia ótica comum ou de contraste de fase. No primeiro caso, temos o método de Rees-Ecker e no segundo o de Brecher-Gronkite. Esse último é considerado um método de referência para contagem de plaquetas.
No método indireto de Fônio, plaquetas são contadas no esfregaço. Contagens eletrônicas, exigindo um aparelho de alto custo, porém é através deste método de contagem que obtemos os resultados mais próximos da realidade do paciente.
Método de Fônio:
É econômico e de fácil execução técnica. Na me sma preparação examinam-se plaquetas, leucócitos e hemácias. Defeitos qualitativos das plaquetas, como formas gigantes e bizarras, são identificados.
O sulfato de magnésio impede a aglutinação das plaquetas cujo nº pode ser avaliado grosseiramente pelo exame do microscópio do esfregaço corado comum.
Técnica:
1.Através da lâmina de esfregaço preparada na sala de coleta, é realizada a coloração pelo Método de May-Grunwald-Giemsa. Secar e examinar sob imersão.
2.Contar mil hemácias e, ao mesmo tempo, as plaquetas encontradas, anotando seu nº.A contagem é feita em vários campos sucessivos seguindo linhas longitudinais em relação à lâmina.
3.Realizar a contagem de hemácias na câmara de Neubauer.

Método de Rees-Ecker:
No sangue convenientemente diluído, as plaquetas são contadas por microscopia ótica comum na câmara de Neubauer.
Técnica:
1. Pipetar 4,0 da solução diluidora no tubo
2. Com micropipeta aspirar 20ml de sangue com EDTA. Limpar sua parede externa com papel de filtro, externamente o volume.
3. Transferir os 20ml de sangue para o tubo com solução diluidora, lavando com ele o interior da pipeta por aspiração e expulsão do líquido. A diluição é de 1:200.
4. Agitar por inversão 2 minutos, no máximo.
5. Encher os retículos da câmara de Neubauer.
6. Sedimentar as plaquetas, repousando a preparação por 15 minutos em uma placa de Petri, contendo um pedaço de algodão umedecido em água (câmara úmida) e em local isento de vibrações.
7. Fazer a contagem microscópica com aumento de 400x em 1/5 de mm2 , conforme indicado para hemácias.. É necessário ter experiência para distinguir as plaquetas de sujidade. Aquelas aparecem como corpos arredondados, ovais ou alongados, totalmente refringentes, com 1,5 mícrons de diâmetro. O ajuste do contraste na microscopia é indispensável para uma boa visualização das plaquetas.
14 Hemostasia e coagulação Parte 4:
Cálculos:
Plaquetas por ml de sangue = Pc x 5 x 10 x 200, ou seja,: nº de plaquetas contadas em 1/5 de mm2 x 10.000.
Quanto maior o nº de elementos contados menor será o erro. Pode ser desejável contar plaquetas em todos os 25 quadrinhos do retículo central, quando o fator final de multiplicação será de 2.000.O retículo oposto poderá ser contado, totalizando em torno de 300 plaquetas contadas.
Interpretação: A trombocitopenia, que é a redução nas plaquetas circulantes (abaixo de 150.000), surge na maioria das vezes de uma ou duas causas gerias. Formação deficiente de plaquetas (como em estados aplásticos, efeito de quimioterapia mielotóxica e por sensibilidade a droga), e uma destruição aumentada de plaquetas na circulação e no baço (originária geralmente de uma sensibilização auto-imune das plaquetas, tornando-as sujeitas a fagocitose por macrófagos). Um aumento do número de plaquetas é denominado trombocitose, e correlaciona-se com formação de trombos intravasculares.
15 Outros exames em hematologia:
Contagem de Reticulócitos:
Os reticulócitos são precursores das hemácias. Contêm no seu interior material reticular, provavelmente uma ribonucleoproteína que não apresenta afinidades pelos corantes comuns. Sua demonstração é feita por coloração supravital. Os reticulócitos presentes no sangue retirado do organismo sofrem morte somática, sendo, porém corados antes que toda atividade vital seja extinta. As anemias que cursam com o reticulócito normal refletem a incapacidade da medula em responder ao estímulo por carência de um fator específico para a formação de eritrócitos (ferro na anemia ferropriva e eritropoetina na insuficiência renal crônica).
O corante usado é o azul de cresil brilhante, associado a um anticoagulante e um preservativo.
Técnica:
1. Colocar no tubo 2 a 3 gotas da solução corante. Em seguida acrescentar 2 a 3 gotas do sangue colhido por punção digital ou sangue colhido com EDTA.
2. Misturar e colocar em banho-maria a 370C de 15 a 30 minutos.
3. Retirar de banho-maria. Misturar novamente e fazer esfregaços da maneira usual.
4. Secar e examinar ao microscópio sob imersão.
5. Contar 10 campos, anotando o número de reticulócitos encontrados. Expressar o resultado em percentagem e número absoluto.
6. Opcionalmente pode fazer coloração de fundo por Giemsa.

Interpretação: o resultado é expresso em percentual e em número absoluto em relação a população de eritrócitos. Sua contagem serve para avaliar de forma efetiva a produção de eritrócitos, sendo útil no controle terapêutico, no diagnóstico diferencial e na classificação das anemias.

Hemossedimentação (VHS):
A hemossedimentação mede a estabilidade da suspensão de hemácias no plasma que, por ser menos denso, favorece a sedimentação dos glóbulos pela ação da gravidade, quando colocados numa pipeta graduada de 0 a 200m com 2,5mm d diâmetro interno e 1 micro-litro (ml) de capacidade.
As hemácias em suspensão no plasma, colocadas na pipeta de Westergren, sofrem sedimentação com velocidade variável em função da concentração de fibrinogênio e globulinas, tamanho e forma das hemácias e alterações elétricas do plasma e dos glóbulos.
Inicialmente ocorre a queda individual das hemácias, seguida pela agregação dos glóbulos com formação de rouleaux e aumento da velocidade de hemossedimentação, que se torna constante para diminuir numa fase final, quando os glóbulos se concentram na porção inferior da pipeta.
O aumento de fibrinogênio e globulinas é também responsável pela aceleração da hemossedimentação que fornece medida grosseira dessas substâncias no plasma.
Técnica:
1. Colher 5ml de sangue do paciente em jejum pela manhã. Não apertar demasiadamente o garrote, evitando estase venosa.
2. Colocar o sangue no frasco com anticoagulante EDTA e agitar por inversão ou movimentos circulares até que se dissolva completamente.
3. Com pipeta de Westergren aspirar sangue até exatamente a marca zero.
4. Colocar a pipeta no suporte de modo a permanecer na posição vertical
5. Marcar o tempo.
6. Fazer a leitura em milímetros após uma hora ao nível da separação do plasma e hemácias. Nas reticulocitoses pode haver uma imprecisão do limite de sedimentação, dificultando a leitura exata.

Pesquisa de Células LE (Lúpus eritematoso):
O lúpus eritematoso é uma doença de etiologia obscura, cujo caráter fundamental é a alteração primária e difusa do tecido colágeno.
Apresenta forma localizada na pele e disseminada com acometimento de vários órgãos, ou seja, lupus eritematoso (LED).
O fenômeno LE é estudado através de técnicas imunológicas, histoquímicas, microfotográficas e cinematográficas.
Quatros grupos de técnicas permitem evidenciar o FAN:
1. Testes citomorfológico: pesquisa de células LE.
2. Fixação de anticorpos fluorescentes sobre o núcleo ou seus componentes.
3. Reação de aglutinação passiva com partículas de látex ou hemácias revestidas com nucleoproteína.
4. Reação antígeno/anticorpo direta, com fixação do complemento e precipitação em agar.
Teste Citomorfológico:
Consiste em incubar os leucócitos com o soro suspeito de conter o FAN. Nas técnicas diretas, células e soro são do próprio paciente. Nas indiretas, leucócitos de outras pessoas são misturados ao soro do paciente.
16 Outros exames em hematologia Parte 2:
Técnica:
1. Colher 8ml de sangue transferindo-os para tubos de ensaio
2. Deixar coagular e incubar a 370C de 30 minutos a uma hora.
3. Fragmentar o coágulo com bastão de vidro e filtrar o material em peneira fina.
4. Centrifugar o filtrado de células em tubo capilar na microcentrífuga durante 5 minutos a 2000 rpm.
5. Desprezar o sobrenadante e realizar esfregaços com porção celular, especialmente leucócitos (a parte clara central entre os eritrócitos e o soro).
6. Corar pelo May-Grunwald Giemsa e pesquisar as células LE através do microscópio.
Pesquisa de Drepanócitos (Hemácias Falciformes):
A hemoglobina S ocorre em 8% dos negros brasileiros, tornando a sua pesquisa um exame bastante solicitado em nosso meio. A demonstração dessa hemoglobina anormal é feita pro três tipos de exames : a eletroforese de hemoglobina que é o método mais eficaz, porém, trabalhoso e caro para ser usado rotineiramente; pelos testes de solubilidade para hemoglobina S e pela pesquisa de drepanócitos.
O fenômeno da falcização trata de uma reorganização das moléculas de hemoglobina em estado reduzido, formando longas cadeias denominadas tactóides, isto é, massas criatalinas. In vitro o fenômeno é demonstrado pelo uso de agentes redutores como metabissulfito de sódio. In vivo a falcização ocorre pela baixa tensão de oxigênio nos capilares, levando ao aparecimento de hemácias falciformes circulantes, o que ocasiona a anemia hemolítica. Solução redutora:

Técnica:
1. Colocar uma gota pequena do sangue sobre a lâmina de microscopia. Gotas maiores fornecem um excesso de líquido sob a lamínula e sobreposição das hemácias
2. Adicionar ao sangue duas gotas do mesmo tamanho de metabissulfito de sódio.
3. Misturar com o canto da lamínula, cobrindo com ela a preparação.
4. Vedar todos os lados da lamínula com esmalte.
5. Fazer a primeira observação ao microscópio, duas horas após a vedação, com aumento de 400x, procurando identificar hemácias falciformes que apresentam prediletação pela área marginal da lamínula se negativo repetir a leitura 6,12 e por fim 24 horas para liberar o resultado.
Interpretação: É dado como negativo ou positivo, conforme presença ou ausência de células falciformes.
17 Referências bibliográficas:
BAIN, B. Células Sanguíneas. São Paulo: Artes Médicas, 1997.
BERNARD, J.J.Manual de Hematologia.São Paulo: 3 ed. Masson do Brasil,1986.
FAILACE, Renato. Hemograma: manual de interpretação. 3 ed. Porto Alegre: Artes Médicas, 1995.
HENRY, J. Diagnósticos clínicos e tratamento por métodos laboratoriais. 19ed. São Paulo: Guanabara Koogan, 1999.
LIMA; et al. Métodos de laboratórios aplicados à clínica. 7 ed. São Paulo: Guanabara Koogan, 1992.
LORENZI, Therezinha. Manual de hematologia: propedêutica e clínica. 2 ed. São Paulo: Medsi, 1999.
RAPAPORT, Samuel I. Hematologia: introdução. 2 ed. São Paulo: Roca, 1990.
VERRASTRO, Therezinha; et all. Hematologia e hemoterapia. São Paulo: Atheneu, 1996.
WILLIAMS; et al. Hematologia. São Paulo: Guanabara Koogan, 1976.